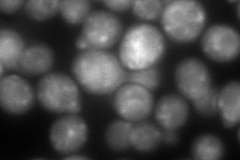
YER101C
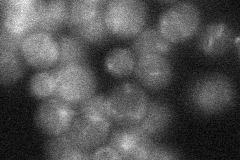
YER101C
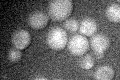
YER101C
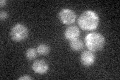
YER101C

View description
Protein that may have a role in targeting of plasma membrane [H+]ATPase (Pma1p) to the plasma membrane, as suggested by analysis of genetic interactions
Localization:
Intensity:
Fold change:
Significance:
-
C’ GFP library in SD

cytosol23.03 -
N' NOP1pr-GFP in SD

cytosol,punctate133.486 -
N' TEF2pr-mCherry in SD
ambiguous,punctate193.476 -
N' NATIVEpr-GFP in SD
punctate23.0379 -
N' TEF2pr-VC and Cyto-VN in SD

punctate58.5966 -
C’ GFP library in SD+DTT

cytosol27.831.2No -
C’ GFP library in SD+H2O2
cytosol26.961.17No -
C’ GFP library in Starvation Media
cytosol29.391.27No -
C’ GFP library on the background of Pup2-DaMP

cytosol -
C’ GFP library on the background of CCT mutant

cytosol22.09530.959101No
